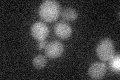
YHR105W
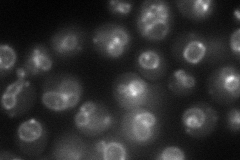
YHR105W
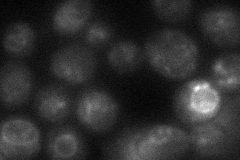
YHR105W
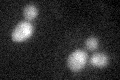
YHR105W

View description
Endosomal protein of unknown function that contains a phox (PX) homology domain and binds to both phosphatidylinositol-3-phosphate (PtdIns(3)P) and proteins involved in ER-Golgi or vesicular transport
Localization:
Intensity:
Fold change:
Significance:
-
C’ GFP library in SD
below threshold16.38 -
N' NOP1pr-GFP in SD
vacuole membrane76.0522 -
N' TEF2pr-mCherry in SD

vacuole membrane103.91 -
N' NATIVEpr-GFP in SD

punctate24.5779 -
N' TEF2pr-VC and Cyto-VN in SD
vacuole membrane40.6106 -
C’ GFP library in SD+DTT
cytosol18.031.1No -
C’ GFP library in SD+H2O2

cytosol14.970.91No -
C’ GFP library in Starvation Media

cytosol18.041.1No -
C’ GFP library on the background of Pup2-DaMP

below threshold -
C’ GFP library on the background of CCT mutant

below threshold16.18950.987988No
